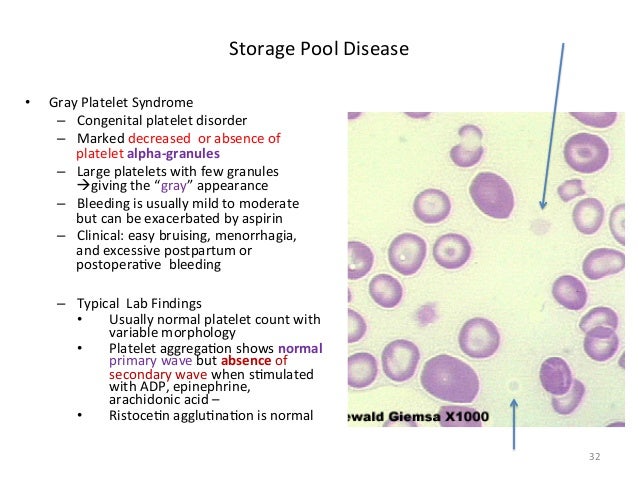

Moreover, these individuals are more likely to have medical complications, such as reacting inappropriately to surgery.Īs a consequence, many children with severe disease don’t live through childhood. In addition, they may present feeding difficulties, leading to decreased growth. Other less frequent symptoms include seizures, decreased or increased sleep, and decreased or increased reflexes.įinally, children affected with AADC deficiency often have learning disabilities, developmental delay, and fail to reach milestones like talking or walking.

In addition, AADC deficiency can cause gastrointestinal symptoms like reflux, diarrhea, or constipation. Symptoms can include excessive salivation and sweating, droopy eyelids called ptosis, nasal congestion, unstable body temperature, low blood pressure, and low blood sugar or hypoglycemia. Other less frequent movement disorders include decreased movement called hypokinesia, increased muscle tone of the limbs or hypertonia, and involuntary movements like tremors, twisting movements called dystonia, writhing movements or athetosis, dance-like movements of hands and feet called chorea.ĪADC deficiency can also affect the autonomic nervous system, which is the part of the nervous system that controls our internal organs. Oculogyric crises can last for hours, and typically occur every 2 to 5 days. One of the most frequent symptoms is hypotonia of the trunk, which means these individuals have very little muscle tone, making them floppy.Īnother frequent symptom is oculogyric crises, which is the abnormal rotation of the eyeballs with elevation of the gaze, as well as uncontrolled movements of the head and neck, agitation, and irritability. The severity of the disease can vary between individuals.ĪADC deficiency mainly causes movement disorders.
The disease affects babies, which most often seem healthy at birth, but then start developing signs and symptoms during the first months of life. Aromatic L-Amino Acid Decarboxylase deficiency, or simply AADC deficiency, is a very rare disease in which there’s a decreased activity of an enzyme called aromatic l-amino acid decarboxylase, or AADC for short.


 0 kommentar(er)
0 kommentar(er)
